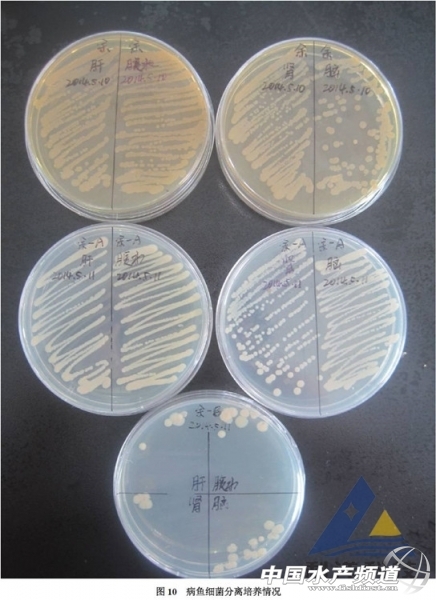
105644oaap59dlw9kt9oak.jpg
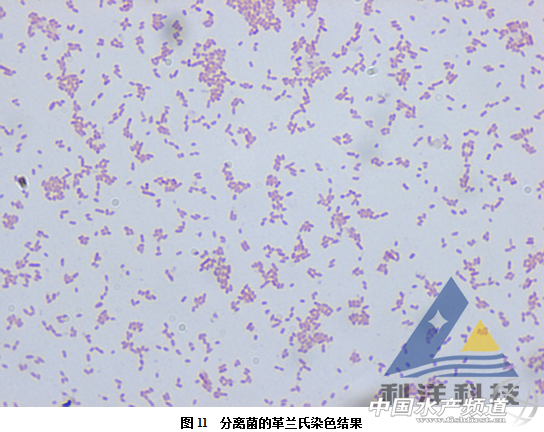
105645tx7k3a3xmst3utut.png

[病例286] 海南省文昌市潭牛鎮一羅非魚養殖池塘,面積15畝,水深2.5米,1臺增氧機(見圖1),2013年12月一次性放規格17尾/斤的羅非魚4.5萬尾,目前規格6~7兩/尾。 2014年5月1日出現死亡,死魚15尾,用解毒劑(黃腐酸、海洋生物生長素、月桂基氨基酸)解毒,同時減料。 5月2日,死亡30尾。 5月3日,死亡130尾。 5月4日,死亡200尾;用硫代硫酸鈉解毒降氨氮。 5月5日,死亡200尾。 5月6日,死亡200尾。 5月7日,死亡240尾。 5月8日,死亡300尾。 5月9日,死亡220尾。 5月10日,死亡160尾,下午3點到現場,測定水溫32℃,簡易試劑盒測水質指標:pH值8.7,亞硝酸鹽0.3mg/L,氨氮0.4mg/L。從塘中取1尾剛死的羅非魚,體表出血,鰓蓋“開天窗”(圖2)。解剖見爛鰓,鰓上附泥,肌肉出血發紅,有腹水,肝臟呈土黃色(見圖3),脾臟呈暗黑色,腸道空虛,膽囊高度充盈,腎臟有少量出血。分別從腹水、肝臟、腎臟和腦接種到腦心浸液培養基進行細菌分離培養。 5月11日,死魚175尾,早上客戶從塘中取2尾魚送檢,其中一尾病魚體表出血(見圖4),解剖見病魚爛鰓,鰓上附著泥土(見圖5),腹腔有腹水,花肝,空腸,出血,膽囊嚴重充盈(見圖6),脾臟腫大,呈暗黑色(見圖7),腎臟出血(見圖8),腦部有大量出血點(見圖9)。另一尾是沒發病的正常魚。分別從腹水、肝臟、腎臟和腦中接種腦心浸液培養基進行細菌分離培養。經24小時培養,病魚各接種組織在培養皿上均長出圓形、邊緣整齊、隆起、表面平滑,灰白色不透明的菌落(見圖10),革蘭氏染色呈陰性、兩端鈍圓的短桿菌(見圖11),經16S rDNA測序鑒定為嗜水氣單胞菌(Aeromonas hydrophila)。正常魚未分離出大量細菌。對分離菌分別進行藥敏試驗,結果顯示,分離菌對“出敗康”、“鰓皮腸利康”、“鰓膚康”、“氟多力”、“菌炎好迪”、“腸苷康”等藥物敏感(見圖12)。 5月11日上午10:00用“氧速保”5瓶調水增氧。 5月12日,死亡150尾。 5月13日,死亡90尾。 5月14日,早上死亡50尾,測水pH值8.3,氨氮和亞硝酸鹽測不出,下午死亡65尾。 5月15日,早上死亡45尾,用聚維酮碘消毒。 5月16日,死亡45尾。 5月17日,早上死亡20尾左右,之后每天死10尾左右,23號以后每天死亡2~3尾,病情得到控制。 分析:1、細菌性敗血癥是淡水魚類的主要疾病,也是池塘養殖羅非魚的重要疾病,今年上半年從海南、云南等地發病羅非魚分離到細菌經鑒定仍然以氣單胞菌為主。 2、本病例發病前期,當時海南長期陰雨天氣,水質不穩定,氨氮、亞硝酸鹽偏高,是羅非魚發生細菌性敗血癥的重要誘發因素。 3、通過水質調控,改善水環境和外用消毒劑控制細菌數量可以控制慢性細菌性敗血癥的死亡,但是死亡數量下降緩慢,本病例在發病初期如果及時配合抗菌藥物內服可能很快降低死亡量,減少損失。(利洋研究所 雷燕 張文文 利洋水產藥店潭牛店 姚勇提供 2014.06.05) 【關鍵字】:羅非魚 嗜水氣單胞菌 水產養殖
|

| 重點推薦 |
| |
免責聲明:
1、凡本網注明“來源:水產前沿網”的所有作品,均為水產前沿網合法擁有版權或有權使用的作品,未經本網授權不得轉載、摘編或利用其它方式使用上述作品。已經本網授權使用作品的,應在授權范圍內使用,并注明“來源:水產前沿網”。違反上述聲明者,本網將追究其相關法律責任。
2、凡本網注明“來源:XXX(非水產前沿網)”的作品,均轉載自其它媒體,轉載目的在于傳遞更多信息,并不代表本網贊同其觀點和對其真實性負責。
3、如本網轉載涉及版權等問題,請作者在15天內來電或來函與水產前沿網聯系。聯系方式:020-85595682。
